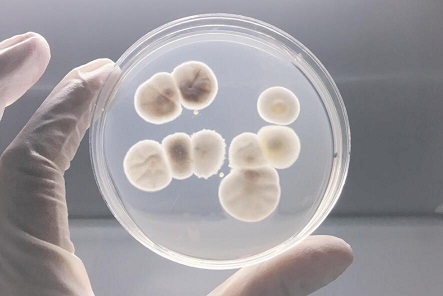
84a7b0e5db9a2a65869ea702dc004b60e054311b.jpg

青霉素等抗生素是现代医学的基础,但细菌同时也在不断进化,其耐药性不断增强。
来自英国、美国、西班牙、瑞士、法国等国的研究人员发现了一种新方法,或许可以抑
制细菌的耐药性。

革兰氏阴性菌是危害性较大的细菌群之一,它们具有一个被称作细胞外被膜的外层,是这种细菌用于防御药物的屏障。这种细胞外被膜包含有抗生素耐药蛋白,可以击退或使抗生素无效,一旦抗生素进入细菌细胞,就会被泵出。研究人员认为,解决细菌耐药性的途径之一便是阻止此类蛋白发生作用。
研究人员搜集了几种抗生素耐药蛋白的编码基因,并把它们置入大肠杆菌中,使其具备抗生素耐药性。然后,研究人员阻止大肠杆菌制造DsbA蛋白质,这使得抗生素耐药蛋白变得不再稳定、无法分解。
研究人员用无法产生DsbA蛋白质的抗生素耐药蛋白感染昆虫幼虫,然后用抗生素进行治疗,它们的存活率得到了提升。这表明,抑制DsbA蛋白质或许可以解决细菌耐药性的问题。
该项研究成果发表在《elife科学》期刊中。世界卫生组织表示,研发针对革兰氏阴性菌的新治疗手段具有重要意义,有可能为人们解决细菌耐药性问题提供新方法。